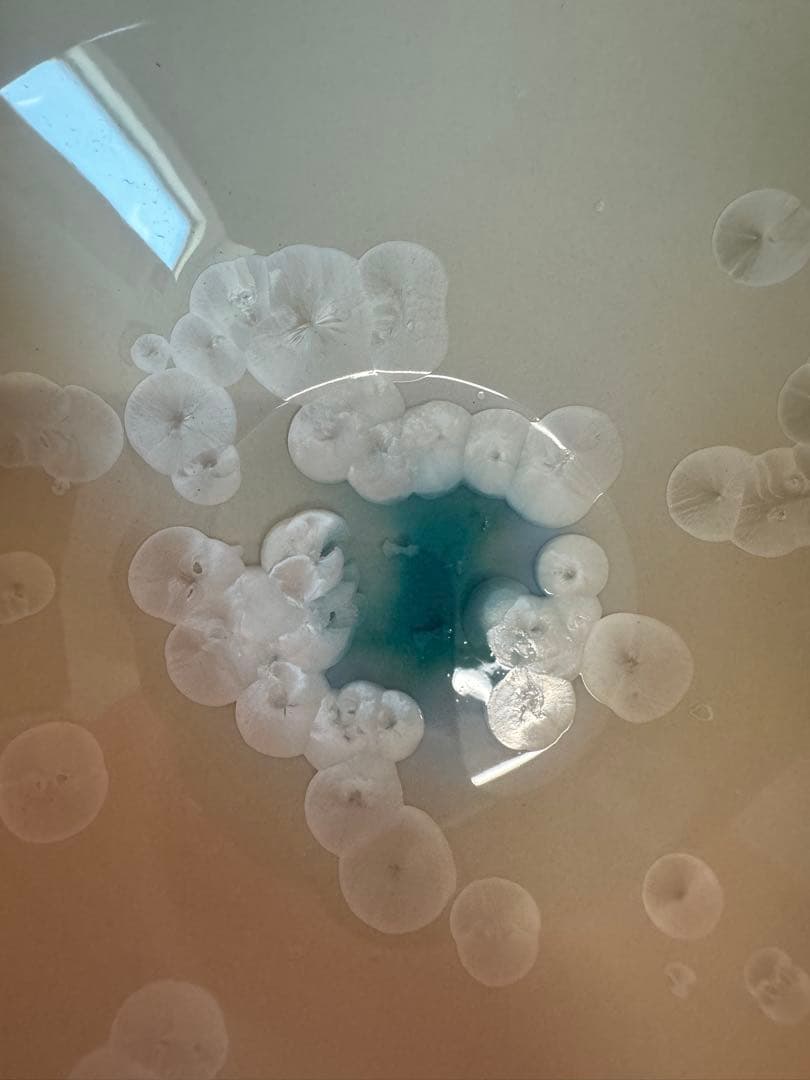
2025 平安橘吉　月華　鉢　未使用

マイストア
変更
お店で受け取る
(送料無料)
配送する
納期目安:
2026.03.27 13:49頃のお届け予定です。
決済方法が、クレジット、代金引換の場合に限ります。その他の決済方法の場合はこちらをご確認ください。
※土・日・祝日の注文の場合や在庫状況によって、商品のお届けにお時間をいただく場合がございます。
2025 平安橘吉 月華 鉢 未使用の詳細情報
状態、詳細につきましては画像にて確認の程よろしくお願い致します。購入後のキャンセルやすり替え防止のため、返品・返金はお断りさせていただきます。。最上位作 浜本洋好 朝鮮唐津ぐい呑。未使用品です箱ありプチプチで丁寧に梱包して、郵送します★即購入歓迎です 24時間以内発送ご検討中の方はぜひコメントお待ちしております(^-^)価格相談もぜひ!希望額ご提示ください!★ 値下交渉はコメントにてお願いいたします。和食器 茶懐石 寿康窯 柳楽泰久作 粉引手 小鉢 五客 共箱 C 9333。茶道具 平安 昭阿弥造 染付 冠香合 共箱 V 9338。商品に問題(破損、写真と一致しないなど)がある場合は、写真添付の上、確認後に返品・返金対応をいたします。九谷焼⭐️杯⭐️七福神⭐️未使用
ベストセラーランキングです
近くの売り場の商品
カスタマーレビュー
オススメ度 4.9点
現在、3519件のレビューが投稿されています。